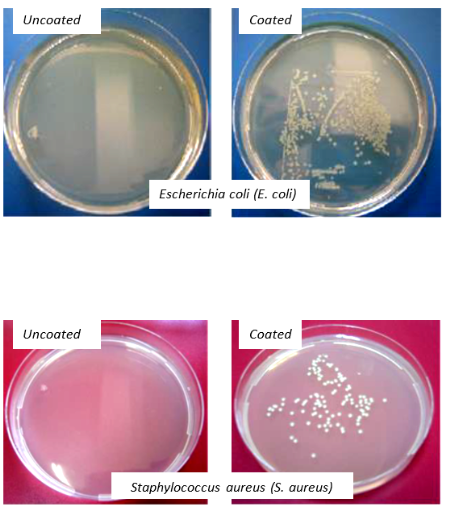

Antifinger Coatings - BYC Group Glass Processing and Coating
Main menu:
Coatings
Anti-Finger Print (AFP) – Anti-Bacterial Coatings
Many materials with polished surface finish (metalized plastics, wood, inox (stainless steel), etc.) are prone to staining with fingerprint oils. Once marked with such stains they lose most of their visual appeal. Fingerprints result from sweat that is transferred to the material surface and are molded by friction ridges on fingers. Most commercially available anti-fingerprint coatings are based on fluorinated compounds due to their oleophobic characters that help repelling oily compounds. However, despite their practical AFP utility, most fluorinated compounds pose environmental and health hazards.
BYC United offers a novel coating solution with comparable AFP characteristics but is completely free from fluorine and its compounds. If desired, the coated surfaces can be tailored with increased roughness to physically avoid finger contact in the first place. AFP films produced thereby are rated up to 3N when Erichsen 318 test pencil is used to test scratch resistance. The adhesive strength of coating satisfies the 5B rating in the ASTM D 3359 standard. Finally the coatings can withstand chemical attack by acids/bases within the pH range 2-12.
In the photograph below two metallic surfaces (Inox 430), uncoated on the left and coated on the right, are shown.

Under ambient light the uncoated surface clearly bears the fingerprint mark. On the other hand, the second surface coated with our AFP solution is completely impervious to staining with fingerprints.
AFP coatings from BYC United can be ordered with the optional antibacterial property. The customers are offered with several alternatives (depending on the application, a combination of them can be used for wide spectrum effect, please inquire) as antibacterial additives;
· Benzalkonium chloride (rated as class III antiseptic by FDA)
· Copper and its alloys
· Silver
· OmadineTM and related compounds (EPA and FDA approved)
When coated samples with antibacterial properties were tested on gram negative Escherichia coli (E. coli) and gram positive Staphylococcus aureus (S. aureus) bacteria, >%99.9 decrease in population was observed for each case.
Tests conducted with coated and uncoated samples for each bacterium species clearly show that coated samples exhibit visibly strong antibacterial effect.